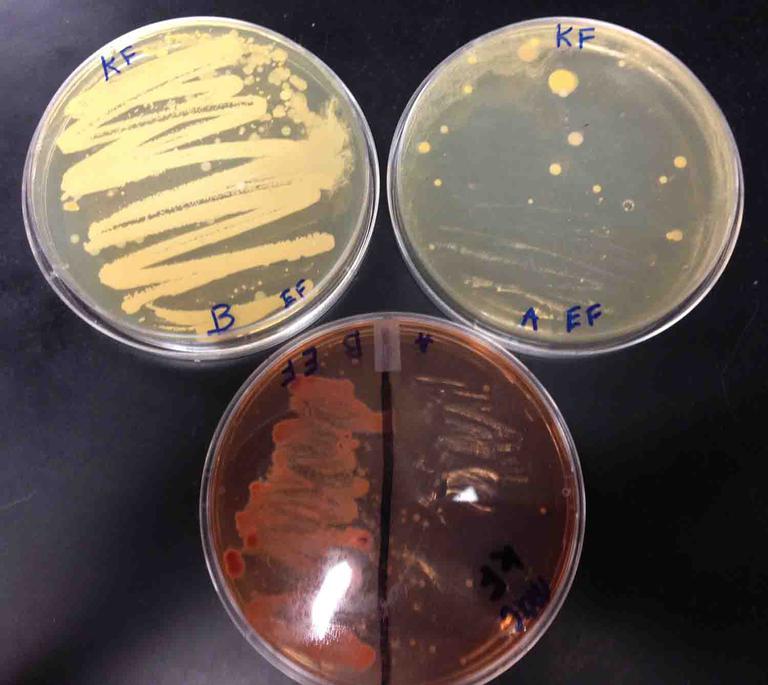

| ||||
Does Shark Light & Easy™ Steam Mop
Kill Bacteria on Floors?
Microbiology in the Home from Science Prof Online
As a college microbiology instructor, I teach a lab about microbial control, how to kill microbes. There are various methods available to students: physical (heat or UV radiation), antibiotics or chemical agents.
Article Summary: Shark® Light & Easy™ is a steam-only mop that claims 99.9% sanitization. But how clean does this steam mop really get floors? Great science experiment for home schooling and classroom use.
Does Shark Light & Easy™ Steam Mops Kill Bacteria?
SPO VIRTUAL CLASSROOMS
 | ||||||
The students choose which control agent(s) they would like to use, then design and conduct an experiment on the effectiveness of their chosen agent.
Recently a student tested how well a steam mop sanitizes his floor and the results were impressive. Below are the methods, results and conclusions from the original experiment.
ATTENTION!: Please see the section on Safety Measures for Working with Live Bacteria before attempting this experiment yourself!
Experiment Conclusion
Steam alone effectively eliminated most of the bacteria, and all of the Gram-negative fecal bacteria, on the floor tile tested.
The main flaw with this experiment is the amount of time that the floor tile was exposed to steam, one minute. It is unlikely that someone cleaning a floor will expose all areas of the floor to steam for an entire minute, so another experiment is currently being carried out, with less steam/mopping time, and comparing the effectiveness of steam alone, cleanser alone and combined steam and cleanser. The results of this additional experiment are available in the article "Does the Shark PRO Steam and Spray Mop Kill Bacteria on Floors".
1. Top left plate is the sample taken from floor before cleaning with steam mop. Creamy horizontal lines on TSY agar are where sample swab contacted media. These lines have grown a solid carpet of bacteria; billions of germs!
2. Top right plate of TSY where "after cleaning" sample was swabbed. This plate shows dramatic reduction in bacteria, only a few bacterial colonies are growing.
3. Bottom plate of MacConkey's medium (MAC) shows "before cleaning" sample on left side of the plate (note carpet of Gram-negative, fecal bacteria) and "after cleaning" sample on bottom right side of plate (no growth).
Additional Microbial Control Resources
- Microbiology In the Home: Tips To Sanitize Your House and Keep Your Family Healthy, Household Microbiology article from Science Prof Online.
- Does the Shark PRO Steam and Spray Mop Kill Bacteria on Floors? from Science Prof Online. Compare the experiment on this page (steam alone) to a mop that uses steam and cleanser.)
- Microbial Control Laboratory Exercise Main Page from the Virtual Microbiology Classroom.
- Shark® Light and Easy™ Steam Mop Official Page.
Safety Measures When Working With Live Bacteria
Please read this section carefully before carrying out the experiment outlined above. Although these plates will be growing bacteria present on hands, once the bacteria begin growing on the agar plates, they will be present in much higher numbers than a person would normally encounter. Therefore, there are some important safety precautions to keep in mind:
- Wear safety goggles and protective gloves when handling plates that are growing bacteria.
- Never open the plates after placing the sample on the agar. Bacteria will be present in large numbers. Some can become airborne and be breathed in or land on areas of the body close to an open plate.
- Keep plates out of the reach of small children and pets.Talk to children about these safety precautions and make sure they know not to ever handle the plates without adult supervision.
- You may place a rubber band around the plates to reduce the likelihood that they will accidentally fall open.
- The top of the refrigerator can be a good place to store incubating plates, as it is up high and usually a bit warm.
- Placing incubating plates in open plastic bag (so aerobic bacteria can get oxygen) is a good measure to keep them safer and reduce odor (bacteria are stinky).
- When the experiment is finished, and you are done with the plates, place them in a zipped up plastic bag (Zip-loc) in the trash. They will run out of food and water eventually and die, but not before generating a lot of stink.
Recently a student tested how well a steam mop sanitizes his floor and the results were impressive. Below are the methods, results and conclusions from the original experiment.
Shark® Light & Easy™ Steam Mop Experiment
For this experiment a Shark Light and Easy steam mop was used to clean a small section of a kitchen floor. The Shark Light & Easy is a steam-only mop. Unlike the Shark® Professional Steam and Spray Mop™, the Shark Light & Easy has no attached cleanser sprayer. Therefore heat only (in the form of steam), no chemical cleanser, was used with this experiment.
The Light and Easy steam mop claims 99.9% sanitization, but the term "sanitize" is ambiguous, and is not defined by the Shark manufacturer. The McGraw-Hill textbook, Microbiology 5/e by Prescott, Klein and Harley defines sanitization as "reduction of the microbial population to a safe level as determined by public health standards". Steam mops typically generate steam at a temperature above 200 degrees Fahrenheit, a temp that will kill most microbes.
SCIENCE PHOTOS
 | ||||||
ANOTHER HOME MICROBIOLOGY EXPERIMENT FROM SPO
TSY agar with sample from dirty dishes on top (note bacterial colonies that grew), and sample from cleaned dishes on bottom.
 | ||||
SCIENCE VIDEOS
VIDEO: How to Interpret MacConkey's Agar (MAC) Bacterial Growth Medium
Go to > Article on MacConkey's Agar
Explore different ways to kill bacteria (physical, chemical and antibiotic)
The Virtual Microbiology Classroom provides a wide range of FREE educational resources including PowerPoint Lectures, Study Guides, Review Questions and Practice Test Questions.
TV show, from Animal Planet, presenting case studies of people with parasitic infections. So interesting, you'll learn about parasitism without even trying!
Check out our FREE
Monsters Inside Me
Homework Assignments
Page last updated 1/2016
 | ||||||
SPO is a FREE science education website. Donations are key in helping us provide this resource with fewer ads.
Please help!
(This donation link uses PayPal on a secure connection.)
See cleaning experiments with the
Tami Port, MS
Chief Executive Nerd of Science Prof Online & College Biology Instructor
Experiment Methods
1. A high traffic area of the kitchen floor was selected, the tile directly in front of the kitchen sink.
2. Before cleaning the tile, a sterile swabs was wiped over the tile surface to obtain a “before cleaning” sample.
3. TSY Agar: That swab was then gently wiped over the surface of a plate of TSY agar (TSY is an all-purpose bacterial growth medium that will grow a wide range of bacteria).
4. MacConkey’s agar (MAC): A line was drawn down the center of a MAC agar media plate. The “before” sample swab was wiped over the surface of the left side of a MAC plate. MacConkey’s is a specialized bacterial growth medium that only grows Gram- bacteria and that can detect the presence of coliform (fecal) bacteria. If using one swab sample for both the TSY and MAC media, it is important to place the sample on the TSY plate FIRST, as the MAC media will kill Gram+ bacteria in your sample.
5. The Shark Light and Easy steam mop was used on the one square foot tile for one minute.
6. The tile was allowed to dry completely.
7. Another sterile swab was wiped over the same tile to obtain an "after cleaning” sample.
8. That swab was then gently wiped over another unused TSY media plate, and over the right side of the MAC plate.
9. The plates were left, bottom (media) side up, in a warm location of the home, for one week. They were then examined for bacterial growth.
Experiment Results
Before Cleaning: On both the TSY and MacConkey’s agar, the "before cleaning" sample showed a thick carpet of bacterial growth. The MacConkey’s bacterial growth was pink, a color change indicating the presence of coliform bacteria.
After Cleaning: On the TSY media, there were only a few bacterial colonies (each having resulted from multiple divisions of a single bacterium). The MacConkey’s agar showed no growth on the “after cleaning” side.